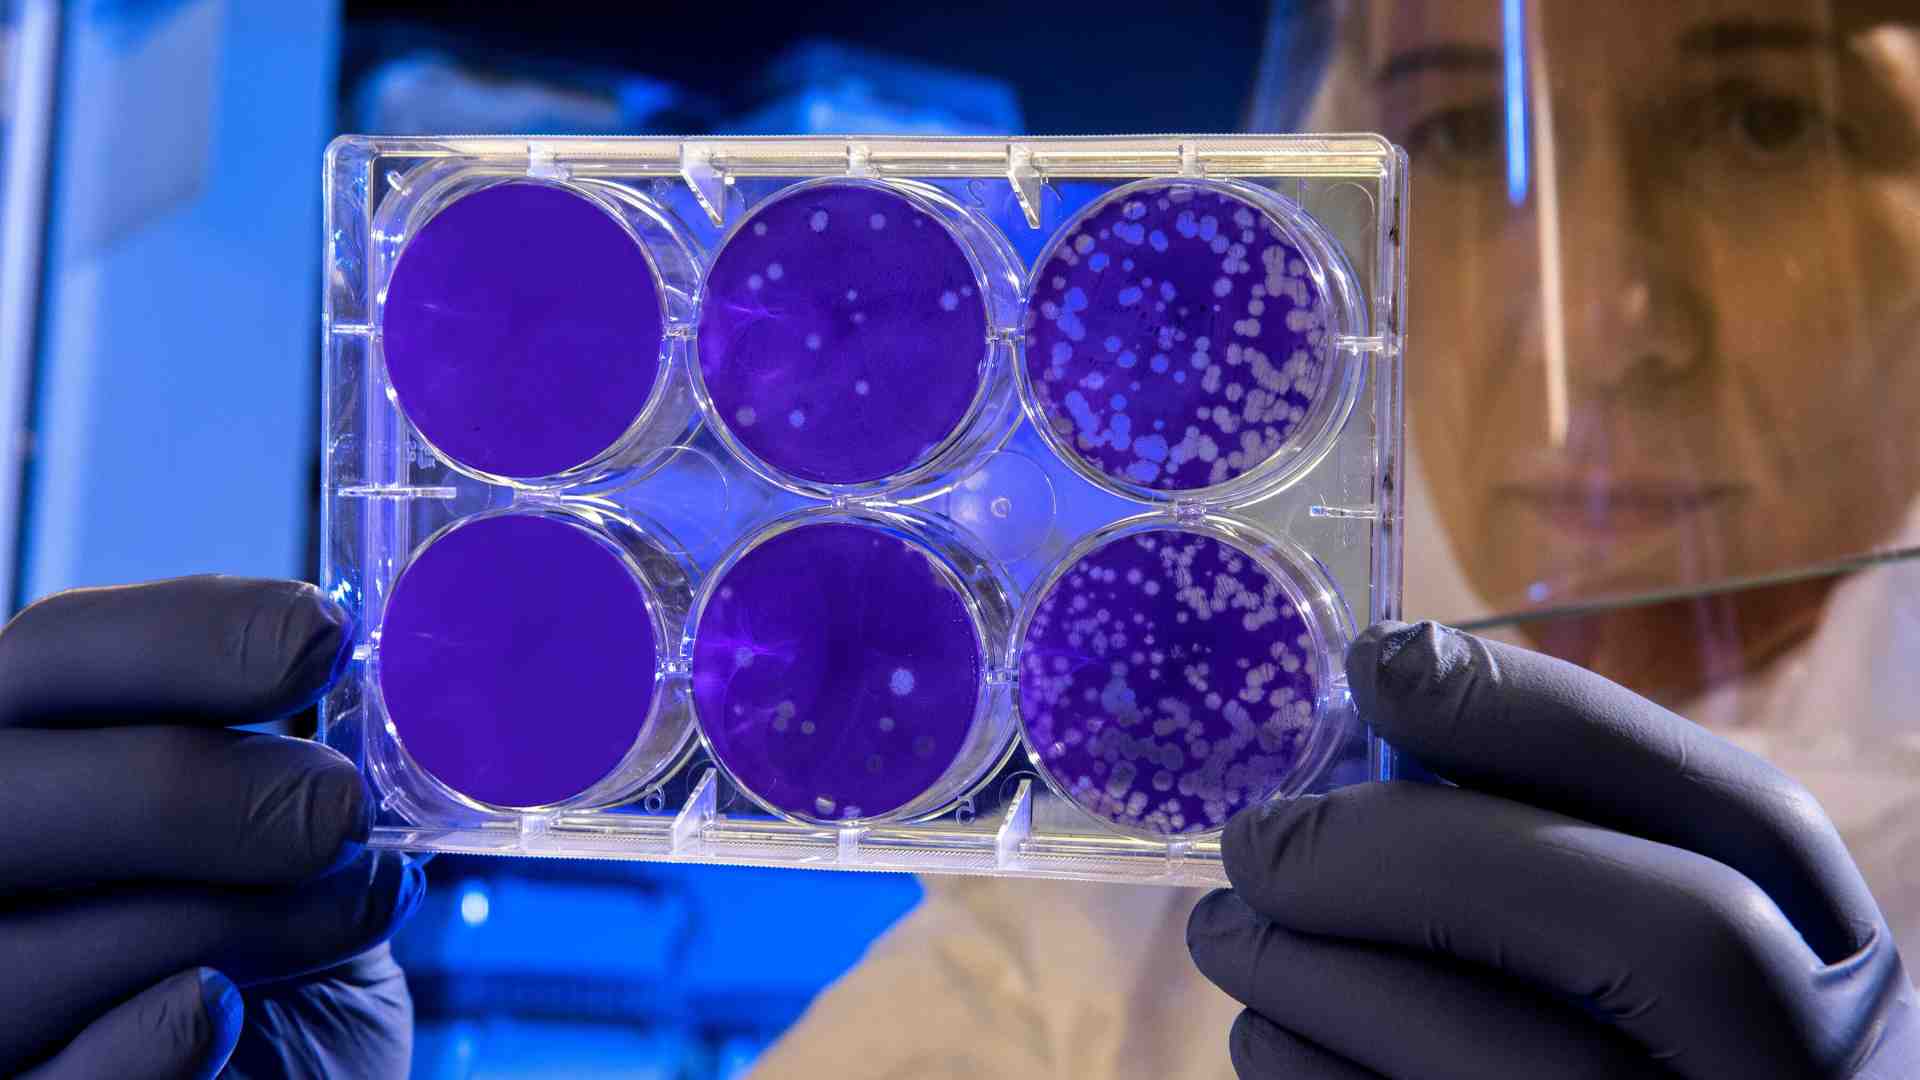
Siamo fatti (anche) di virus

22.09.2024
Analisi
Virus stagionali, Covid attivo, nuove possibili pandemie esigono vigilanza e visione strategica. Che stanno venendo meno. Perché è a rischio la più grande opera pubblica dell’Italia repubblicana
16.08.2024
17.05.2024
Cattivi scienziati
26.04.2024
Cattivi scienziati
25.03.2024
Lo studio
Un nuovo studio mostra l'altro lato della zoonosi: zibetti o pangolini, spesso accusati di essere i responsabili di epidemie e pandemie, potrebbero essere in realtà più vittime che carnefici
02.02.2024
Cattivi scienziati
04.01.2024
Cattivi scienziati
17.11.2021
di MARTA BICEGOÈ iniziata la campagna vaccinale per proteggersi dal virus. Dose gratuita per soggetti a rischio